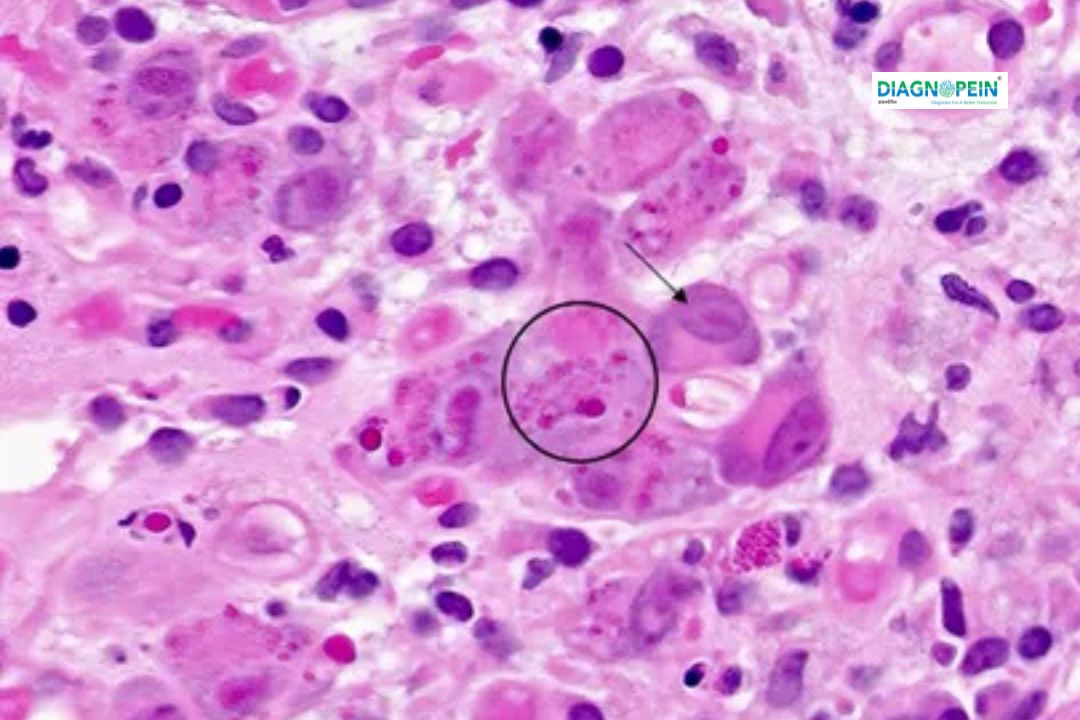

The CMV IgG Avidity test measures the strength of IgG antibody binding to the CMV virus, helping identify whether the infection is new or past — crucial for pregnancy and immune health manage


The CMV IgG Avidity Test is a specialized blood test used to determine the timing of a Cytomegalovirus (CMV) infection. It helps differentiate between a recent infection and a past (long-standing) infection by measuring how strongly IgG antibodies attach to the CMV virus. This information is especially important for pregnant women, newborns, and immunocompromised individuals, guiding doctors in making accurate diagnostic and treatment decisions.
When Is the Test Recommended?
Your doctor may recommend a CMV IgG Avidity test if:
You have tested positive for CMV IgM or CMV IgG.
You’re pregnant and your doctor wants to confirm when the infection occurred.
You’re planning for an organ or stem-cell transplant.
You show symptoms like fatigue, fever, or swollen lymph nodes suggestive of CMV.
How Is the Test Done?
It’s a simple blood test. A sample is collected and tested using advanced immunoassay methods such as ECLIA or ELISA to measure both CMV IgG levels and their avidity strength. Results are usually available within a few days.
What Do CMV IgG Avidity Test Results Mean?
Low avidity → Indicates a recent or ongoing CMV infection.
High avidity → Suggests an old infection and immunity development.
Intermediate avidity → May indicate a transitional phase; retesting after a few weeks might be recommended.
Key Benefits of CMV IgG Avidity Testing
Helps differentiate recent vs. past infection
Crucial in pregnancy risk assessment
Assists in transplant screening and immune monitoring
Supports timely treatment decisions and counseling
Highly accurate and validated testing methods
Trusted by doctors for pregnancy and immune monitoring
Quick and reliable reporting of results
Expert lab professionals for test interpretation
Easy booking and home sample collection available
Low avidity means that the infection occurred recently, within the past 3 to 4 months. In pregnancy, this can be a concern as it raises the possibility of transmitting CMV to the developing baby.
This means you had a past CMV infection, but there is no current or recent infection. This combination is typically not dangerous, especially in pregnancy, as it suggests immunity to CMV.
If you are CMV IgG positive and IgM negative during pregnancy, it suggests a past infection. This is usually reassuring as the risk of transmitting the virus to the fetus is low.
The test is a simple blood test where a sample is taken and analyzed in the lab to measure the strength of the IgG antibodies' binding to the CMV virus.
A high avidity result indicates that the CMV infection is not recent, usually occurring more than three months ago. This is generally less concerning in pregnancy as it means the risk of transmission to the fetus is low.